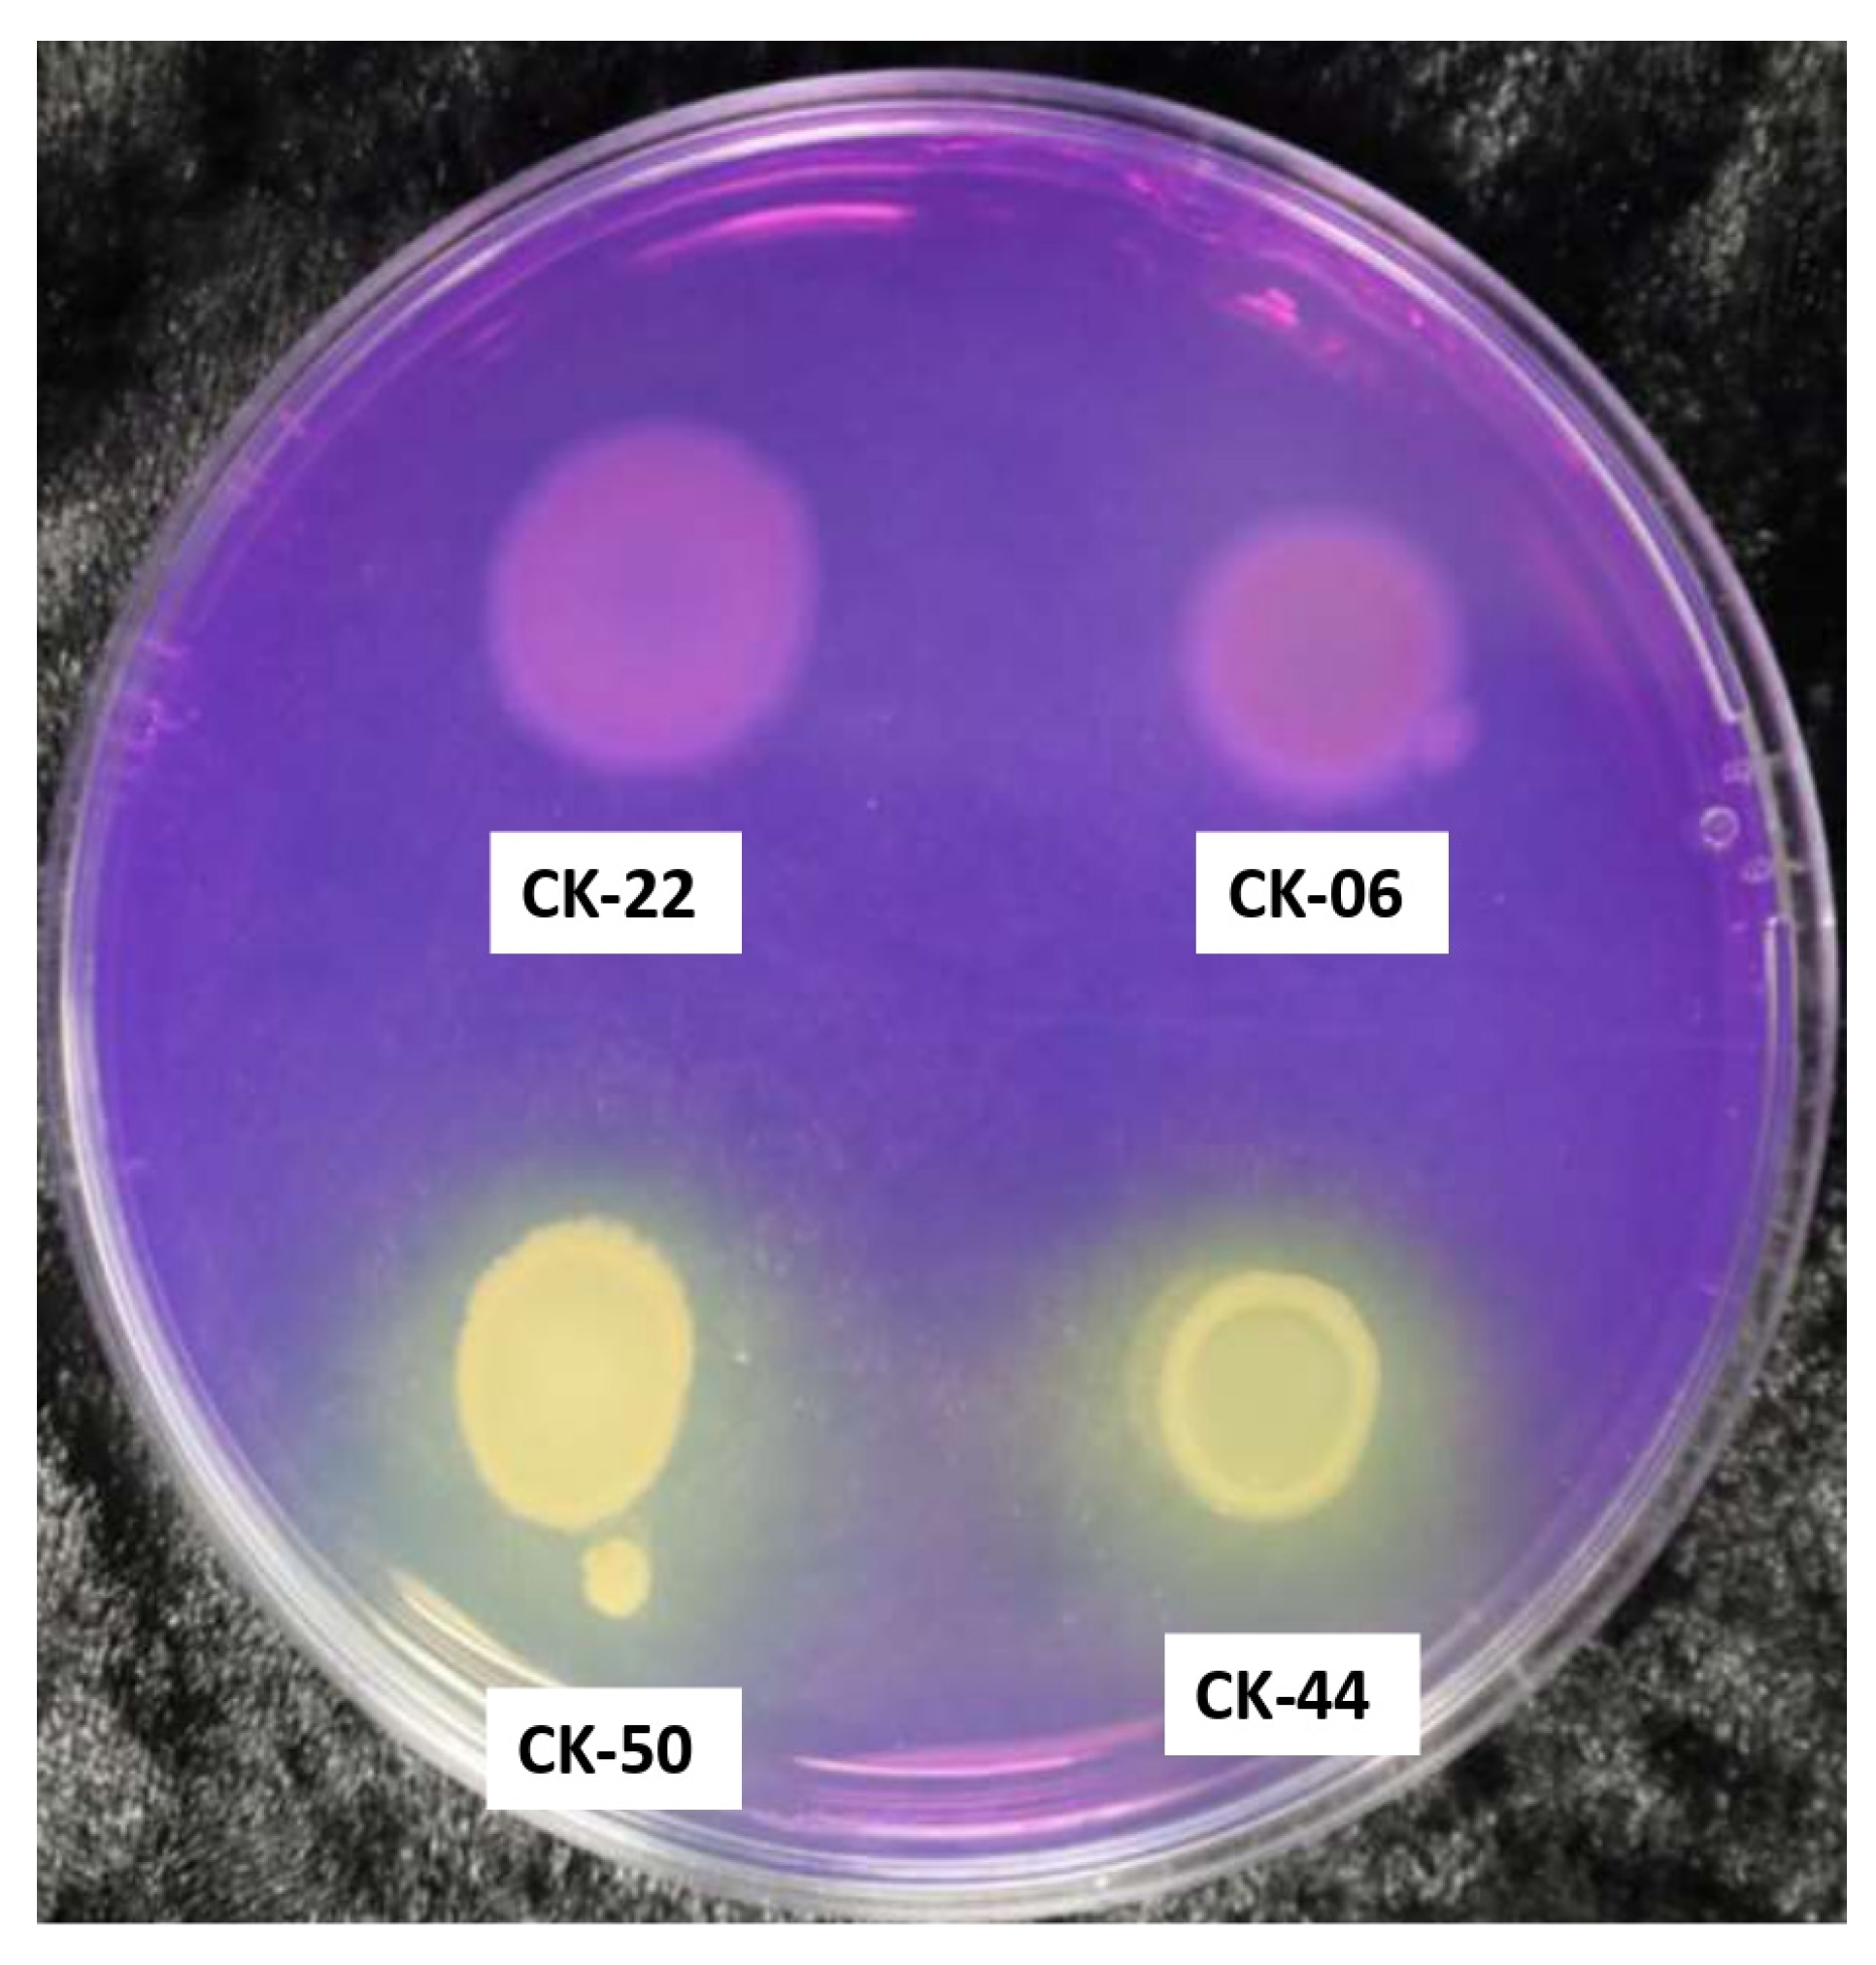
Microbiolres 15 00173 g002

Rhizobacterial Isolates from the Native Plant Ceanothus velutinus Promote Growth in Two Genotypes of Tall Fescue
Abstract
1. Introduction
2. Materials and Methods
2.1. Plant Material and Bacterial Isolates
2.2. Bacterial Treatment and Plant Growth Promotion Experiment
2.3. Collection of Data for Plant Growth Parameters
2.4. Soil Analysis
2.5. Screening for Sulfur-Oxidizing Capability
3. Results
3.1. Effect of Bacterial Isolates on Tiller Number and Biomass of Lawn-Type Tall Fescue Blend
3.2. Effect of Bacterial Isolates on Tiller Number and Biomass of Forage-Type Tall Fescue Armory
3.3. Soil Nutrient Analysis
3.4. Sulfur-Oxidizing Capability
4. Discussion
5. Conclusions
Supplementary Materials
Author Contributions
Funding
Data Availability Statement
Acknowledgments
Conflicts of Interest
References
- Wang, L.; Wang, L.; Li, Y.; Wang, J. A Century-Long Analysis of Global Warming and Earth Temperature Using a Random Walk with Drift Approach. Decis. Anal. J. 2023, 7, 100237. [Google Scholar] [CrossRef]
- de Gorter, H.; Drabik, D.; Just, D. Biofuel Policies and Food Grain Commodity Prices 2006–2012: All Boom and No Bust? AgBioForum 2013, 16, 1–13. [Google Scholar]
- Kanojia, A.; Dijkwel, P. Abiotic Stress Responses Are Governed by Reactive Oxygen Species and Age. In Annual Plant Reviews Online; John Wiley and Sons Inc.: Hoboken, NJ, USA, 2018; pp. 1–32. ISBN 9781119312994. [Google Scholar]
- Dhankher, O.P.; Foyer, C.H. Climate Resilient Crops for Improving Global Food Security and Safety. Plant Cell Environ. 2018, 41, 877–884. [Google Scholar] [CrossRef] [PubMed]
- van Dijk, M.; Morley, T.; Rau, M.L.; Saghai, Y. A Meta-Analysis of Projected Global Food Demand and Population at Risk of Hunger for the Period 2010–2050. Nat. Food 2021, 2, 494–501. [Google Scholar] [CrossRef] [PubMed]
- Hossain, M.E.; Shahrukh, S.; Hossain, S.A. Chemical Fertilizers and Pesticides: Impacts on Soil Degradation, Groundwater, and Human Health in Bangladesh. In Environmental Degradation: Challenges and Strategies for Mitigation; Singh, V.P., Yadav, S., Yadav, K.K., Yadava, R.N., Eds.; Springer International Publishing: Cham, Switzerland, 2022; pp. 63–92. ISBN 978-3-030-95542-7. [Google Scholar]
- Raza, A.; Razzaq, A.; Mehmood, S.S.; Zou, X.; Zhang, X.; Lv, Y.; Xu, J. Impact of Climate Change on Crops Adaptation and Strategies to Tackle Its Outcome: A Review. Plants 2019, 8, 34. [Google Scholar] [CrossRef]
- Khan, A.; Panthari, D.; Sharma, R.S.; Punetha, A.; Singh, A.V.; Upadhayay, V.K. Chapter 6—Biofertilizers: A Microbial-Assisted Strategy to Improve Plant Growth and Soil Health. In Advanced Microbial Techniques in Agriculture, Environment, and Health Management; Chandra Pandey, S., Pande, V., Sati, D., Samant, M., Eds.; Academic Press: Cambridge, MA, USA, 2023; pp. 97–118. ISBN 978-0-323-91643-1. [Google Scholar]
- Wille, L.; Messmer, M.M.; Studer, B.; Hohmann, P. Insights to Plant–Microbe Interactions Provide Opportunities to Improve Resistance Breeding against Root Diseases in Grain Legumes. Plant Cell Environ. 2019, 42, 20–40. [Google Scholar] [CrossRef]
- Vocciante, M.; Grifoni, M.; Fusini, D.; Petruzzelli, G.; Franchi, E. The Role of Plant Growth-Promoting Rhizobacteria (PGPR) in Mitigating Plant’s Environmental Stresses. Appl. Sci. 2022, 12, 1231. [Google Scholar] [CrossRef]
- Lugtenberg, B.; Kamilova, F. Plant-Growth-Promoting Rhizobacteria. Annu. Rev. Microbiol. 2009, 63, 541–556. [Google Scholar] [CrossRef]
- Kuan, K.B.; Othman, R.; Abdul Rahim, K.; Shamsuddin, Z.H. Plant Growth-Promoting Rhizobacteria Inoculation to Enhance Vegetative Growth, Nitrogen Fixation and Nitrogen Remobilisation of Maize under Greenhouse Conditions. PLoS ONE 2016, 11, e0152478. [Google Scholar] [CrossRef]
- Glick, B.R. Plant Growth-Promoting Bacteria: Mechanisms and Applications. Scientifica 2012, 2012, 963401. [Google Scholar] [CrossRef]
- Orozco-Mosqueda, M.d.C.; Santoyo, G.; Glick, B.R. Recent Advances in the Bacterial Phytohormone Modulation of Plant Growth. Plants 2023, 12, 606. [Google Scholar] [CrossRef] [PubMed]
- Bhattacharyya, C.; Banerjee, S.; Acharya, U.; Mitra, A.; Mallick, I.; Haldar, A.; Haldar, S.; Ghosh, A.; Ghosh, A. Evaluation of Plant Growth Promotion Properties and Induction of Antioxidative Defense Mechanism by Tea Rhizobacteria of Darjeeling, India. Sci. Rep. 2020, 10, 15536. [Google Scholar] [CrossRef] [PubMed]
- Compant, S.; Cassan, F.; Kostić, T.; Johnson, L.; Brader, G.; Trognitz, F.; Sessitsch, A. Harnessing the Plant Microbiome for Sustainable Crop Production. Nat. Rev. Microbiol. 2024, 23, 9–23. [Google Scholar] [CrossRef] [PubMed]
- Acharya, B.R.; Gill, S.P.; Kaundal, A.; Sandhu, D. Strategies for Combating Plant Salinity Stress: The Potential of Plant Growth-Promoting Microorganisms. Front. Plant Sci. 2024, 15, 1406913. [Google Scholar] [CrossRef]
- Burlakoti, S.; Devkota, A.R.; Poudyal, S.; Kaundal, A. Beneficial Plant–Microbe Interactions and Stress Tolerance in Maize. Appl. Microbiol. 2024, 4, 1000–1015. [Google Scholar] [CrossRef]
- Ganesh, J.; Singh, V.; Hewitt, K.; Kaundal, A. Exploration of the Rhizosphere Microbiome of Native Plant Ceanothus velutinus—an Excellent Resource of Plant Growth-Promoting Bacteria. Front. Plant Sci. 2022, 13, 979069. [Google Scholar] [CrossRef]
- Devkota, A.R.; Wilson, T.; Kaundal, A. Soil and Root Microbiome Analysis and Isolation of Plant Growth-Promoting Bacteria from Hybrid Buffaloberry (Shepherdia utahensis ‘Torrey’) across Three Locations. Front. Microbiol. 2024, 15, 1396064. [Google Scholar] [CrossRef]
- Baldi, D.S.; Humphrey, C.E.; Kyndt, J.A.; Moore, T.C. Native Plant Gardens Support More Microbial Diversity and Higher Relative Abundance of Potentially Beneficial Taxa Compared to Adjacent Turf Grass Lawns. Urban. Ecosyst. 2023, 26, 807–820. [Google Scholar] [CrossRef]
- Stein, B.A. States of the Union: Ranking America’s Biodiversity; NatureServe: Arlington, VA, USA, 2002. [Google Scholar]
- Rupp, L.; Wheaton, A. Nurturing Native Plants: A Guide to Vegetative Propagation of Native Woody Plants in Utah; Utah State University Extension: Logan, UT, USA, 2014; pp. 1–150. [Google Scholar]
- Kratsch, H.A.; Graves, W.R. Nitrogen Fixation as a Stress-Avoidance Strategy among Actinorhizal (Non-Legume) Trees and Shrubs. J. Crop Improv. 2004, 10, 281–304. [Google Scholar] [CrossRef]
- Chen, J.-J.; Kratsch, H.; Norton, J.; Sun, Y.; Rupp, L. Nodulation and Plant Growth of Shepherdia ×utahensis ‘Torrey’ Topdressed with Controlled-Release Fertilizer. HortScience 2020, 55, 1956–1962. [Google Scholar] [CrossRef]
- Hooper, V.H.; Endter-Wada, J.; Johnson, C.W. Theory and Practice Related to Native Plants: A Case Study of Utah Landscape Professionals. Landsc. J. 2008, 27, 127–141. [Google Scholar] [CrossRef]
- Paudel, A.; Sun, Y.; Rupp, L.A.; Carman, J.G.; Love, S.L. Vegetative Propagation of Ceanothus velutinus Using Stem Cuttings. Nativ. Plants J. 2022, 23, 123–129. [Google Scholar] [CrossRef]
- Ganesh, J.; Hewitt, K.; Devkota, A.R.; Wilson, T.; Kaundal, A. IAA-Producing Plant Growth Promoting Rhizobacteria from Ceanothus velutinus Enhance Cutting Propagation Efficiency and Arabidopsis Biomass. Front. Plant Sci. 2024, 15, 1374877. [Google Scholar] [CrossRef] [PubMed]
- Lou, Y.; Chen, L.; Xu, Q.; Zhang, X. Genotypic Variation of Morphological Traits in Tall Fescue (Festuca arundinacea Schreb.) Accessions. HortScience 2015, 50, 512–516. [Google Scholar] [CrossRef]
- Stuedemann, J.A.; Hoveland, C.S. Fescue Endophyte: History and Impact on Animal Agriculture. J. Prod. Agric. 1988, 1, 39–44. [Google Scholar] [CrossRef]
- Waller, J.C. Endophyte Effects on Cattle. In Tall Fescue for the Twenty-First Century; American Society of Agronomy: Madison, WI, USA, 2009; Volume 53, pp. 289–310. [Google Scholar]
- Pedersen Jeffrey, F.; Lacefield, G.D.; Ball, D.M. A Review of the Agronomic Characteristics of Endophyte-Free and Endophyte-Infected Tall Fescue. Appl. Agric. Res. 1990, 5, 188–194. [Google Scholar]
- Zhang, Z.-F.; Rao, L.-Q.; Xiao, J. Research on the Sterilization Method for Endophytic Fungi of Tall Fescue Seeds. In Multifunctional Grasslands in a Changing World II; China Scientific Books: Hong Kong, China, 2008; p. 629. [Google Scholar]
- Olsen, S.R.; Cole, C.V.; Watandbe, F.; Dean, L. Estimation of Available Phosphorus in Soil by Extraction with Sodium Bicarbonate. J. Chem. Inf. Model. 1954, 53, 1689–1699. [Google Scholar]
- Haby, V.A. Soil NO3-N Analysis in CA(OH)2 Extracts by the Chromotropic Acid Method. Soil Sci. Soc. Am. J. 1989, 53, 308–310. [Google Scholar] [CrossRef]
- Poudel, S. Organic Matter Determination (Walkley-Black Method). 2020. Available online: https://www.researchgate.net/publication/339941885_Organic_Matter_determination_Walkley_-Black_method?channel=doi&linkId=5e6e50fc92851c6ba7063044&showFulltext=true (accessed on 1 September 2024).
- Lindsay, W.L.; Norvell, W.A. Development of a DTPA Soil Test for Zinc, Iron, Manganese, and Copper. Soil Sci. Soc. Am. J. 1978, 42, 421–428. [Google Scholar] [CrossRef]
- Vidyalakshmi, R.; Sridar, R. Isolation and Characterization of Sulphur Oxidizing Bacteria. J. Cult. Collect. 2007, 5, 73–77. [Google Scholar]
- Chaudhary, S.; Dhanker, R.; Tanvi; Goyal, S.L. Characterization and Optimization of Culture Conditions for Sulphur Oxidizing Bacteria After Isolation from Rhizospheric Mustard Soil, Decomposing Sites and Pit House. World Acad. Sci. Eng. Technol. Int. J. Biol. Biomol. Agric. Food Biotechnol. Eng. 2017, 11, 427–431. [Google Scholar]
- Backer, R.; Rokem, J.S.; Ilangumaran, G.; Lamont, J.; Praslickova, D.; Ricci, E.; Subramanian, S.; Smith, D.L. Plant Growth-Promoting Rhizobacteria: Context, Mechanisms of Action, and Roadmap to Commercialization of Biostimulants for Sustainable Agriculture. Front. Plant Sci. 2018, 9, 1473. [Google Scholar] [CrossRef] [PubMed]
- Wei, X.; Xie, B.; Wan, C.; Song, R.; Zhong, W.; Xin, S.; Song, K. Enhancing Soil Health and Plant Growth through Microbial Fertilizers: Mechanisms, Benefits, and Sustainable Agricultural Practices. Agronomy 2024, 14, 609. [Google Scholar] [CrossRef]
- Shaharoona, B.; Jamro, G.M.; Zahir, Z.A.; Arshad, M.; Memon, K.S. Effectiveness of Various Pseudomonas Spp. and Burkholderia Caryophylli Containing ACC-Deaminase for Improving Growth and Yield of Wheat (Triticum aestivum I.). J. Microbiol. Biotechnol. 2007, 17, 1300. [Google Scholar]
- Shruti, K.; Arun, K.; Yuvneet, R. Potential Plant Growth-Promoting Activity of Rhizobacteria Pseudomonas Sp. in Oryza Sativa. J. Nat. Prod. Plant Resour. 2013, 3, 38–50. [Google Scholar]
- Mirza, M.S.; Mehnaz, S.; Normand, P.; Prigent-Combaret, C.; Moënne-Loccoz, Y.; Bally, R.; Malik, K.A. Molecular Characterization and PCR Detection of a Nitrogen-Fixing Pseudomonas Strain Promoting Rice Growth. Biol. Fertil. Soils 2006, 43, 163–170. [Google Scholar] [CrossRef]
- Cole, M.L. Use of Plant Growth-Promoting Rhizobacteria in Tall Fescue and Bermudagrass Forage Systems. Master’s Thesis, Auburn University, Auburn, AL, USA, 2021. [Google Scholar]
- Liu, W.; Sun, J.; Ding, L.; Luo, Y.; Chen, M.; Tang, C. Rhizobacteria (Pseudomonas sp. SB) Assist Phytoremediation of Oily-Sludge-Contaminated Soil by Tall Fescue (Testuca arundinacea L.). Plant Soil 2013, 371, 533–542. [Google Scholar] [CrossRef]
- Groover, W.; Held, D.; Lawrence, K.; Carson, K. Plant Growth-Promoting Rhizobacteria: A Novel Management Strategy for Meloidogyne incognita on Turfgrass. Pest Manag. Sci. 2020, 76, 3127–3138. [Google Scholar] [CrossRef]
- Arora, N.K.; Mishra, J.; Singh, P.; Fatima, T. Salt-Tolerant Plant Growth-Promoting Pseudomonas atacamensis KSS-6 in Combination with Organic Manure Enhances Rice Yield, Improves Nutrient Content and Soil Properties under Salinity Stress. J. Basic Microbiol. 2024, 64, 2300767. [Google Scholar] [CrossRef]
- Chandra, D.; Srivastava, R.; Glick, B.R.; Sharma, A.K. Drought-Tolerant Pseudomonas spp. Improve the Growth Performance of Finger Millet (Eleusine coracana (L.) Gaertn.) Under Non-Stressed and Drought-Stressed Conditions. Pedosphere 2018, 28, 227–240. [Google Scholar] [CrossRef]
- Wintermans, P.C.A.; Bakker, P.A.H.M.; Pieterse, C.M.J. Natural Genetic Variation in Arabidopsis for Responsiveness to Plant Growth-Promoting Rhizobacteria. Plant Mol. Biol. 2016, 90, 623–634. [Google Scholar] [CrossRef] [PubMed]
- Ramírez-Sánchez, D.; Gibelin-Viala, C.; Roux, F.; Vailleau, F. Genetic Architecture of the Response of Arabidopsis thaliana to a Native Plant-Growth-Promoting Bacterial Strain. Front. Plant Sci. 2023, 14, 1266032. [Google Scholar] [CrossRef] [PubMed]
- Vidyalakshmi, R.; Paranthaman, R.; Bhakyaraj, R. Sulphur Oxidizing Bacteria and Pulse Nutrition—A Review. World J. Agric. Sci. 2009, 5, 270–278. [Google Scholar]
- Patel, K.; Kapadia, C.; Patel, N.; Patel, D.; Parmar, P.; Datta, R.; Alharbi, S.; Ansari, M. Effect of Supplementing Sulphur-Oxidizing Bacteria with Different Sulphur Sources on the Growth and Development of Chickpea (Cicer arietinum). Plant Stress 2024, 12, 100433. [Google Scholar] [CrossRef]
- Nadeem, S.M.; Hanif, A.; Khan, M.Y.; Waqas, M.; Ahmad, Z.; Ashraf, M.R.; Naveed, M. Elemental Sulphur with Sulphur Oxidizing Bacteria Enhances Phosphorus Availability and Improves Growth and Yield of Wheat in Calcareous Soil. Arch. Agron. Soil Sci. 2022, 69, 1494–1502. [Google Scholar] [CrossRef]
- Chaudhary, S.; Dhanker, R.; Singh, K.; Brar, B.; Goyal, S. Characterization of Sulfur-oxidizing Bacteria Isolated from Mustard (Brassica juncea L.) Rhizosphere Having the Capability of Improving Sulfur and Nitrogen Uptake. J. Appl. Microbiol. 2022, 133, 2814–2825. [Google Scholar] [CrossRef]
- Koenig, R.; Hurst, C.; Barnhill, J.; Kitchen, B.; Winger, M.; Johnson, M. Fertilizer Management for Alfalfa; Utah State University Extension: Logan, UT, USA, 1999. [Google Scholar]
- Upadhayay, V.K.; Singh, A.V.; Khan, A.; Sharma, A. Contemplating the Role of Zinc-Solubilizing Bacteria in Crop Biofortification: An Approach for Sustainable Bioeconomy. Front. Agron. 2022, 4, 903321. [Google Scholar] [CrossRef]
- Ben Zineb, A.; Lamine, M.; Khallef, A.; Hamdi, H.; Ahmed, T.; Al-Jabri, H.; Alsafran, M.; Mliki, A.; Sayadi, S.; Gargouri, M. Harnessing Rhizospheric Core Microbiomes from Arid Regions for Enhancing Date Palm Resilience to Climate Change Effects. Front. Microbiol. 2024, 15, 1362722. [Google Scholar] [CrossRef]
- Khan, A.L.; Asaf, S.; Abed, R.M.M.; Ning Chai, Y.; Al-Rawahi, A.N.; Mohanta, T.K.; Al-Rawahi, A.; Schachtman, D.P.; Al-Harrasi, A. Rhizosphere Microbiome of Arid Land Medicinal Plants and Extra Cellular Enzymes Contribute to Their Abundance. Microorganisms 2020, 8, 213. [Google Scholar] [CrossRef]

| Isolates | IAA (µg/mL) | PSI | NH3 (µg/mL) | NF | SP | ACC | PA | Cat | |
|---|---|---|---|---|---|---|---|---|---|
| Media | nifH+ | ||||||||
| CK-06 | 10.95 ±0.02 | 2.4 ±0.23 | 56.84 ±5.35 | ++ | + | ++ | +++ | - | ++ |
| CK-22 | 23.78 ±0.36 | 2.40 ±0.39 | 17.34 ±2.86 | +++ | - | ++ | ++ | - | +++ |
| CK-44 | 28.79 ±0.54 | 2.01 ±0.13 | 50.32 ±5.83 | +++ | - | ++ | + | - | +++ |
| CK-50 | 10.31 ±0.23 | 2.43 ±0.03 | 100.69 ±8.39 | +++ | - | ++ | + | ++ | +++ |
| Lawn-Type Tall Fescue Blend—First Harvest | ||||||||
|---|---|---|---|---|---|---|---|---|
| Treatment | Mean Tiller No | SE Tiller No | Mean Fresh WT | SE Fresh WT | Mean Dry WT | SE Dry WT | Mean Height | SE Height |
| Control | 7.42 b | 0.87 | 6.10 b | 0.56 | 1.66 b | 0.20 | 37.00 a | 2.63 |
| CK-06 | 18.67 a | 2.83 | 11.38 a | 1.12 | 3.37 a | 0.31 | 35.93 a | 1.68 |
| CK-22 | 15.83 a | 1.75 | 11.38 a | 1.50 | 3.20 a | 0.40 | 40.50 a | 1.72 |
| CK-44 | 14.25 ab | 1.45 | 10.61 ab | 1.49 | 2.84 ab | 0.36 | 41.58 a | 2.12 |
| CK-50 | 15.67 ab | 2.75 | 10.12 ab | 1.44 | 2.69 ab | 0.39 | 37.86 a | 2.65 |
| Lawn-Type Tall Fescue—Second Harvest | ||||||||
| Mean Fresh WT | SE Fresh WT | Mean Dry WT | SE Dry WT | |||||
| Control | 6.78 b | 0.5 | 1.71 b | 0.13 | ||||
| CK-06 | 15.52 a | 1.26 | 3.87 a | 0.32 | ||||
| CK-22 | 12.61 a | 1.43 | 3.32 a | 0.41 | ||||
| CK-44 | 14.10 a | 1.37 | 3.51 a | 0.36 | ||||
| CK-50 | 14.13 a | 2.07 | 3.51 a | 0.5 | ||||
| Forage-Type Tall Fescue Armory—First harvest | ||||||||
| Treatment | Mean | SE | Mean | SE | Mean | SE | Mean | SE |
| Tiller No | Tiller No | Fresh WT | Fresh WT | Dry WT | Dry WT | Height | Height | |
| Control | 4.9 b | 0.4 | 5.1 b | 0.6 | 1.2 b | 0.1 | 52.0 a | 2.5 |
| CK-06 | 7.1 ab | 0.7 | 7.5 ab | 0.5 | 2.0 a | 0.1 | 57.0 a | 2.8 |
| CK-22 | 8.1 a | 0.7 | 8.2 a | 0.7 | 2.1 a | 0.2 | 53.8 a | 2.3 |
| CK-44 | 6.2 ab | 0.5 | 5.8 ab | 0.8 | 1.4 ab | 0.2 | 48.3 a | 3.1 |
| CK-50 | 7.6 a | 0.5 | 7.3 ab | 0.8 | 1.9 a | 0.2 | 50.4 a | 2.7 |
| Forage-Type Tall Fescue Armory—Second harvest | ||||||||
| Mean | SE | Mean | SE | Mean | SE | Mean | SE | |
| Tiller No | Tiller No | Fresh WT | Fresh WT | Dry WT | Dry WT | Height | Height | |
| Control | 12.5 b | 1.3 | 6.5 b | 0.7 | 1.7 b | 0.2 | 43.2 a | 1.9 |
| CK-06 | 15.9 ab | 2.1 | 9.8 ab | 0.9 | 2.3 ab | 0.2 | 49.0 a | 2.3 |
| CK-22 | 22.9 a | 2.3 | 12.7 a | 1.3 | 3.1 a | 0.4 | 47.7 a | 2.0 |
| CK-44 | 16.6 ab | 1.5 | 7.6 b | 0.7 | 1.9 b | 0.2 | 46.2 a | 2.3 |
| CK-50 | 19.3 ab | 1.6 | 9.7 ab | 0.7 | 2.5 ab | 0.2 | 46.7 a | 2.2 |
| Treatment | pH | Salinity- ECe (dS/m) | P | K | N | Zn | Fe | Cu | Mn | S | OM (%) |
|---|---|---|---|---|---|---|---|---|---|---|---|
| (mg/Kg) | (mg/Kg) | (mg/Kg) | (mg/Kg) | (mg/Kg) | (mg/Kg) | (mg/Kg) | (mg/Kg) | ||||
| Control | 8.1 | 1.72 | 8.08 | 566 | 31 | 1.3 | 5.53 | 0.71 | 4.37 | 5.6 | 1.8 |
| CK-06 | 7.7 | 5.58 | 13 | 494 | 153 | 1.41 | 5.48 | 0.66 | 4.5 | 11.3 | 1.8 |
| CK-22 | 8.1 | 1.05 | 9.98 | 556 | 12.4 | 1.52 | 5.65 | 0.79 | 5.64 | 5.3 | 1.7 |
| CK-44 | 8.1 | 1.53 | 9.86 | 616 | 23.2 | 1.51 | 5.87 | 0.88 | 6.03 | 9.9 | 1.8 |
| CK-50 | 8 | 1.82 | 7.33 | 529 | 32.6 | 1.33 | 5.39 | 0.74 | 5.17 | 6.9 | 1.4 |
| Treatment | pH | Salinity- ECe (dS/m) | P | K | N | Zn | Fe | Cu | Mn | S | OM (%) |
|---|---|---|---|---|---|---|---|---|---|---|---|
| (mg/Kg) | (mg/Kg) | (mg/Kg) | (mg/Kg) | (mg/Kg) | (mg/Kg) | (mg/Kg) | (mg/Kg) | ||||
| Control | 8 | 2.09 | 7.18 | 60.07 | 22 | 0.9 | 4.31 | 0.57 | 3.21 | 23.7 | 1.3 |
| CK-06 | 8.1 | 1.29 | 5.57 | 61.2 | 7.86 | 9.98 | 4.65 | 0.60 | 3.25 | 12.2 | 1.5 |
| CK-22 | 8.1 | 1.38 | 3.96 | 60.4 | 12.4 | 0.91 | 4.25 | 0.58 | 2.69 | 20.5 | 1.1 |
| CK-44 | 8.0 | 2.16 | 4.83 | 63.6 | 30.9 | 0.96 | 4.22 | 0.59 | 2.89 | 24.7 | 1.2 |
| CK-50 | 8.1 | 1.59 | 4.83 | 66.2 | 22.1 | 0.93 | 4.29 | 0.55 | 3.09 | 14.4 | 1.3 |
| Isolates | 24 h | 72 h | 120 h |
|---|---|---|---|
| CK-06 | - | - | - |
| CK-22 | - | - | - |
| CK-44 | 1.39 ±0.10 | 1.32 ±0.05 | 1.40 ±0.05 |
| CK-50 | 1.32 ±0.04 | 1.42 ±0.08 | 1.63 ±0.00 |
Disclaimer/Publisher’s Note: The statements, opinions and data contained in all publications are solely those of the individual author(s) and contributor(s) and not of MDPI and/or the editor(s). MDPI and/or the editor(s) disclaim responsibility for any injury to people or property resulting from any ideas, methods, instructions or products referred to in the content. |
© 2024 by the authors. Licensee MDPI, Basel, Switzerland. This article is an open access article distributed under the terms and conditions of the Creative Commons Attribution (CC BY) license (https://creativecommons.org/licenses/by/4.0/).
Share and Cite
Devkota, A.R.; Kaur, S.; Kaundal, A. Rhizobacterial Isolates from the Native Plant Ceanothus velutinus Promote Growth in Two Genotypes of Tall Fescue. Microbiol. Res. 2024, 15, 2607-2618. https://doi.org/10.3390/microbiolres15040173
Devkota AR, Kaur S, Kaundal A. Rhizobacterial Isolates from the Native Plant Ceanothus velutinus Promote Growth in Two Genotypes of Tall Fescue. Microbiology Research. 2024; 15(4):2607-2618. https://doi.org/10.3390/microbiolres15040173
Chicago/Turabian StyleDevkota, Ananta Raj, Sukhmanjot Kaur, and Amita Kaundal. 2024. "Rhizobacterial Isolates from the Native Plant Ceanothus velutinus Promote Growth in Two Genotypes of Tall Fescue" Microbiology Research 15, no. 4: 2607-2618. https://doi.org/10.3390/microbiolres15040173
APA StyleDevkota, A. R., Kaur, S., & Kaundal, A. (2024). Rhizobacterial Isolates from the Native Plant Ceanothus velutinus Promote Growth in Two Genotypes of Tall Fescue. Microbiology Research, 15(4), 2607-2618. https://doi.org/10.3390/microbiolres15040173






